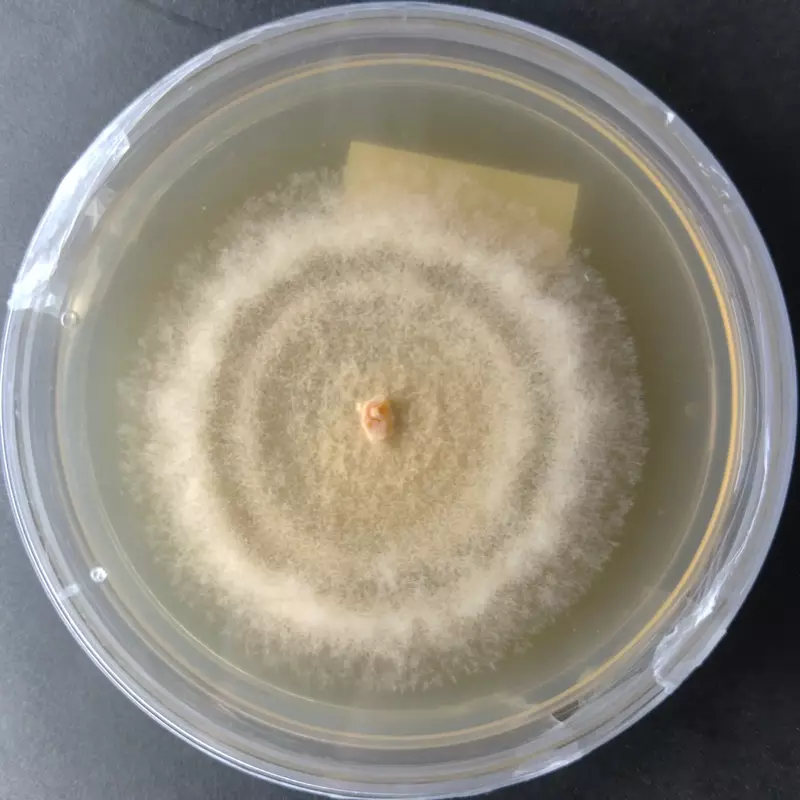

Laetiporus sulphureus (Chicken of the Woods) โ Pure Culture Plate
Premium Laetiporus sulphureus (Chicken of the Woods) pure culture plate for gourmet and specialty mushroom growers. Known for its bright orange shelves, meaty texture, and savory chicken-like flavor, this strain is perfect for commercial cultivation, research, and culinary innovation.
๐ Proudly prepared and stored at Agripie Agrosystem LLP, India ๐ฎ๐ณ
The Laetiporus sulphureus (Chicken of the Woods) โ Pure Culture Plate provides a verified, contamination-free strain of one of the worldโs most recognizable wild mushrooms.
Renowned for its distinctive yellow-orange fruiting bodies and delicious, meat-like taste, Chicken of the Woods is a high-value gourmet species with growing interest among chefs and mushroom enthusiasts.
This culture exhibits vigorous mycelial growth, fast colonization on hardwood substrates, and excellent shelf formation when conditions are optimized. Ideal for research institutions, commercial cultivation setups, and advanced hobby growers exploring specialty mushroom production.
Features:
Authentic Laetiporus sulphureus strain (Chicken of the Woods)
Pure, lab-tested culture free from contamination
Fast-growing mycelium suitable for hardwood substrates
Produces striking orange-yellow fruiting bodies
Meaty flavor ideal for gourmet and vegan recipes
Suitable for both research and experimental cultivation
๐ Proudly prepared and stored at Agripie Agrosystem LLP, India ๐ฎ๐ณ

|
| 
